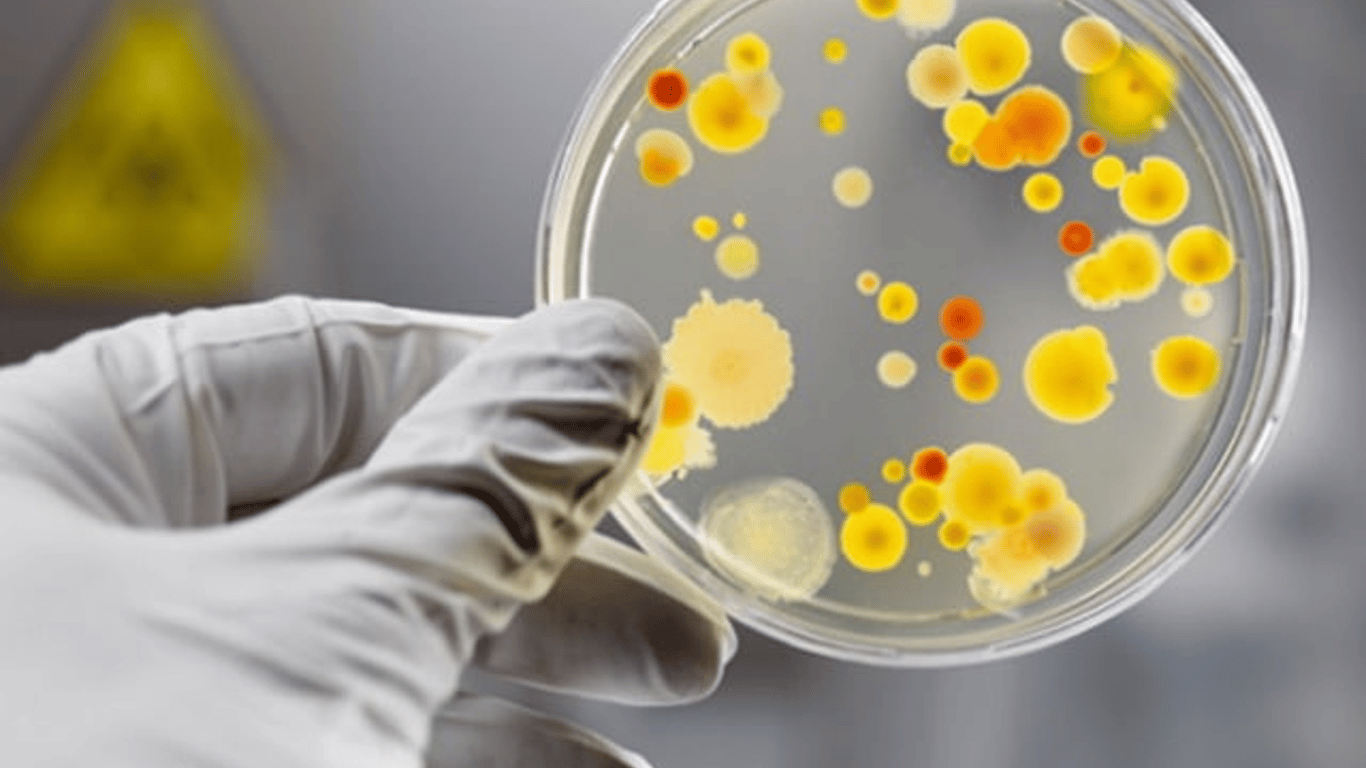

Подарунок від шефа: в Одеській області вечірка в честь дня народження обернулася сальмонелою
В Одеській області минулого тижня в Ізмаїльскому районі п’ять дорослих отруїлися сальмонелою після святкування дня народження. Жителі області в селі Приморське орендували приміщення на базі відпочинку “Мегапарус”.
Про це повідомляє ДУ "Одеський обласний центр контролю та профілактики хвороб МОЗ України".
Читайте також: На курортах Одещини відпочивальники скаржаться на нашестя сонечок
Всіх постраждалих шпиталізували до обласного інфекційного відділення. Вони пов’язують своє захворювання з вживанням готових страв. За їхніми словами їжа була приготована в домашніх умовах та зберігались з порушенням температурного режиму. В осередку проведено протиепідемічні заходи з лабораторним контролем.
Зазначимо, що захворюваність на гострі кишкові інфекції в області, у порівнянні з попереднім тижнем, зросла на 20,8% з урахуванням дітей до 17 років, де ріст на 42,9%. Водночас серед дорослого населення рівень захворюваності знизився на 26,1%.
Нагадаємо:
- Морська вода на пляжах Одеси відповідає санітарним вимогам. Фахівці обласного центру контролю і профілактики хвороб Міністерства охорони здоров'я України перевірили її стан на 22 пляжах міста.
Більше оперативних новин шукайте в Telegram і Viber Новини.LIVE Odesa.